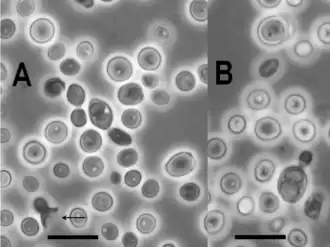

Novakomyces olei
| Novakomyces olei | ||||||||||||
|---|---|---|---|---|---|---|---|---|---|---|---|---|
Kultur von Novakomyces olei NCAIM Y.02187T. Ein zweisporiger Ascus ist in beiden Bildern sichtbar. In Bild A ist zudem mit dem Pfeil ein Rest eines Ascus zu sehen, der durch Konjugation seiner Mutterzelle mit dem Spross gebildet wurde. Messstriche sind 10 μm lang. | ||||||||||||
| Systematik | ||||||||||||
| ||||||||||||
| Wissenschaftlicher Name der Klasse | ||||||||||||
| Novakomycetes | ||||||||||||
| Dlauchy, Péter & Čadež | ||||||||||||
| Wissenschaftlicher Name der Ordnung | ||||||||||||
| Novakomycetales | ||||||||||||
| Dlauchy, Péter & Čadež | ||||||||||||
| Wissenschaftlicher Name der Familie | ||||||||||||
| Novakomycetaceae | ||||||||||||
| Dlauchy, Péter & Čadež | ||||||||||||
| Wissenschaftlicher Name der Gattung | ||||||||||||
| Novakomyces | ||||||||||||
| Dlauchy, Péter & Čadež | ||||||||||||
| Wissenschaftlicher Name der Art | ||||||||||||
| Novakomyces olei | ||||||||||||
| Dlauchy, Péter & Čadež |
Die Novakomycetes sind eine 2021 neu beschriebene Klasse der Schlauchpilze mit im Moment (September 2023) nur einer beschriebenen Art (Novakomyces olei).
Merkmale
Es sind hefeartige Pilze. Die Schläuche (Asci) sind entweder nicht konjugiert oder werden nach erfolgter Konjugation von Mutterzelle und seiner sprossenden Zelle gebildet. Die Asci enthalten eine oder zwei fast kugelige oder ellipsoide Sporen, die zerfließen. Die Hefezellen sind fast kugelig oder ellipsoid. Die ungeschlechtliche Vermehrung erfolgt durch vielseitige Sprossung, die innerseits (enteroblastisch) geschieht. Die Zellwand besteht aus zwei Schichten. Echte Hyphen oder auch Pseudohyphe sind nicht vorhanden. Urease wird produziert, auf Anfärbung mit Echtblausalz B (Diazonium Blue B) reagieren die Zellen negativ. Das wichtigste Coenzym Q ist Q10. Es werden stärkeähnliche Verbindungen produziert.[1]
Ökologie und Verbreitung
Novakomyces olei, die bisher einzige beschriebene Art der Novakomycetes, wurde aus Olivenöl aus Spanien isoliert. Es sind noch keine anderen Vorkommen bekannt.[1]
Systematik
Die Novakomycetes bilden eine Klasse innerhalb der Taphrinomycotina und sind das Schwestertaxon zu den Spalthefen (Schizosaccharomycetes).[1] Sie wurde erst 2021 von Dénes Dlauchy, Gábor Péter und Neža Čadež wissenschaftlich beschrieben. Bisher ist nur die Ordnung Novakomycetales mit der einzigen Familie Novakomycetaceae und der einzigen Gattung Novakomyces bekannt. Es ist bisher nur die Art Novakomyces olei beschrieben.[2][3]
Etymologie
Der Gattungsname Novakomyces setzt sich aus dem Familiennamen Novák und dem griechischen Wort mykos (μύκης) für Pilz zusammen. Er ehrt den Wissenschaftler E. K. Novák, der sich mit Hefen und deren Taxonomie befasste. Der Artname olei bezieht sich auf das Vorkommen in Olivenöl.[1]
Einzelnachweise
- ↑ a b c d Neža Čadež, Dénes Dlauchy, Miha Tome, Gábor Péter: Novakomyces olei sp. nov., the First Member of a Novel Taphrinomycotina Lineage. In: Microorganisms. Band 9, Nr. 2, 2021, S. 301, doi:10.3390/microorganisms9020301.
- ↑ Novakomyces olei. In: MycoBank. Mycobank, abgerufen am 23. September 2023.
- ↑ N. N. Wijayawardene, K. D. Hyde, D. Q. Dai, M. Sánchez-García, B. T. Goto, R. K. Saxena, M. Erdogdu, F. Selçuk, K. C. Rajeshkumar, A. Aptroot, J. Blaszkowski, N. Boonyuen, G. A. da Silva, F. A. de Souza, W. Dong, D. Ertz, D. Haelewaters, E. B. G. Jones, S. C. Karunarathna, P. M. Kirk, M. Kukwa, J. Kumla, D. V Leontyev, H. T. Lumbsch, S. S. N. Maharachchikumbura, F. Marguno, P. Martínez-Rodríguez, A. Mešić, J. S. Monteiro, F. Oehl, J. Pawłowska, D. Pem, W. P. Pfliegler, A. J. L. Phillips, A. Pošta, M. Q. He, J. X. Li, M. Raza, P. P. Sruthi, S. Suetrong, N. Suwannarach, L. Tedersoo, V. Thiyagaraja, S. Tibpromma, Z. Tkalčec, Y. Tokarev, D. N. Wanasinghe, D. S. A. Wijesundara, S. D. M. K. Wimalaseana, H. Madrid, G. Q. Zhang, Y. Gao, I. Sánchez-Castro, L. Z. Tang, M. Stadler, A. Yurkov, M. Thines.: Outline of Fungi and fungus-like taxa – 2021. In: Mycosphere. Band 13, Nr. 1, 2022, S. 53–453, doi:10.5943/mycosphere/13/1/2.